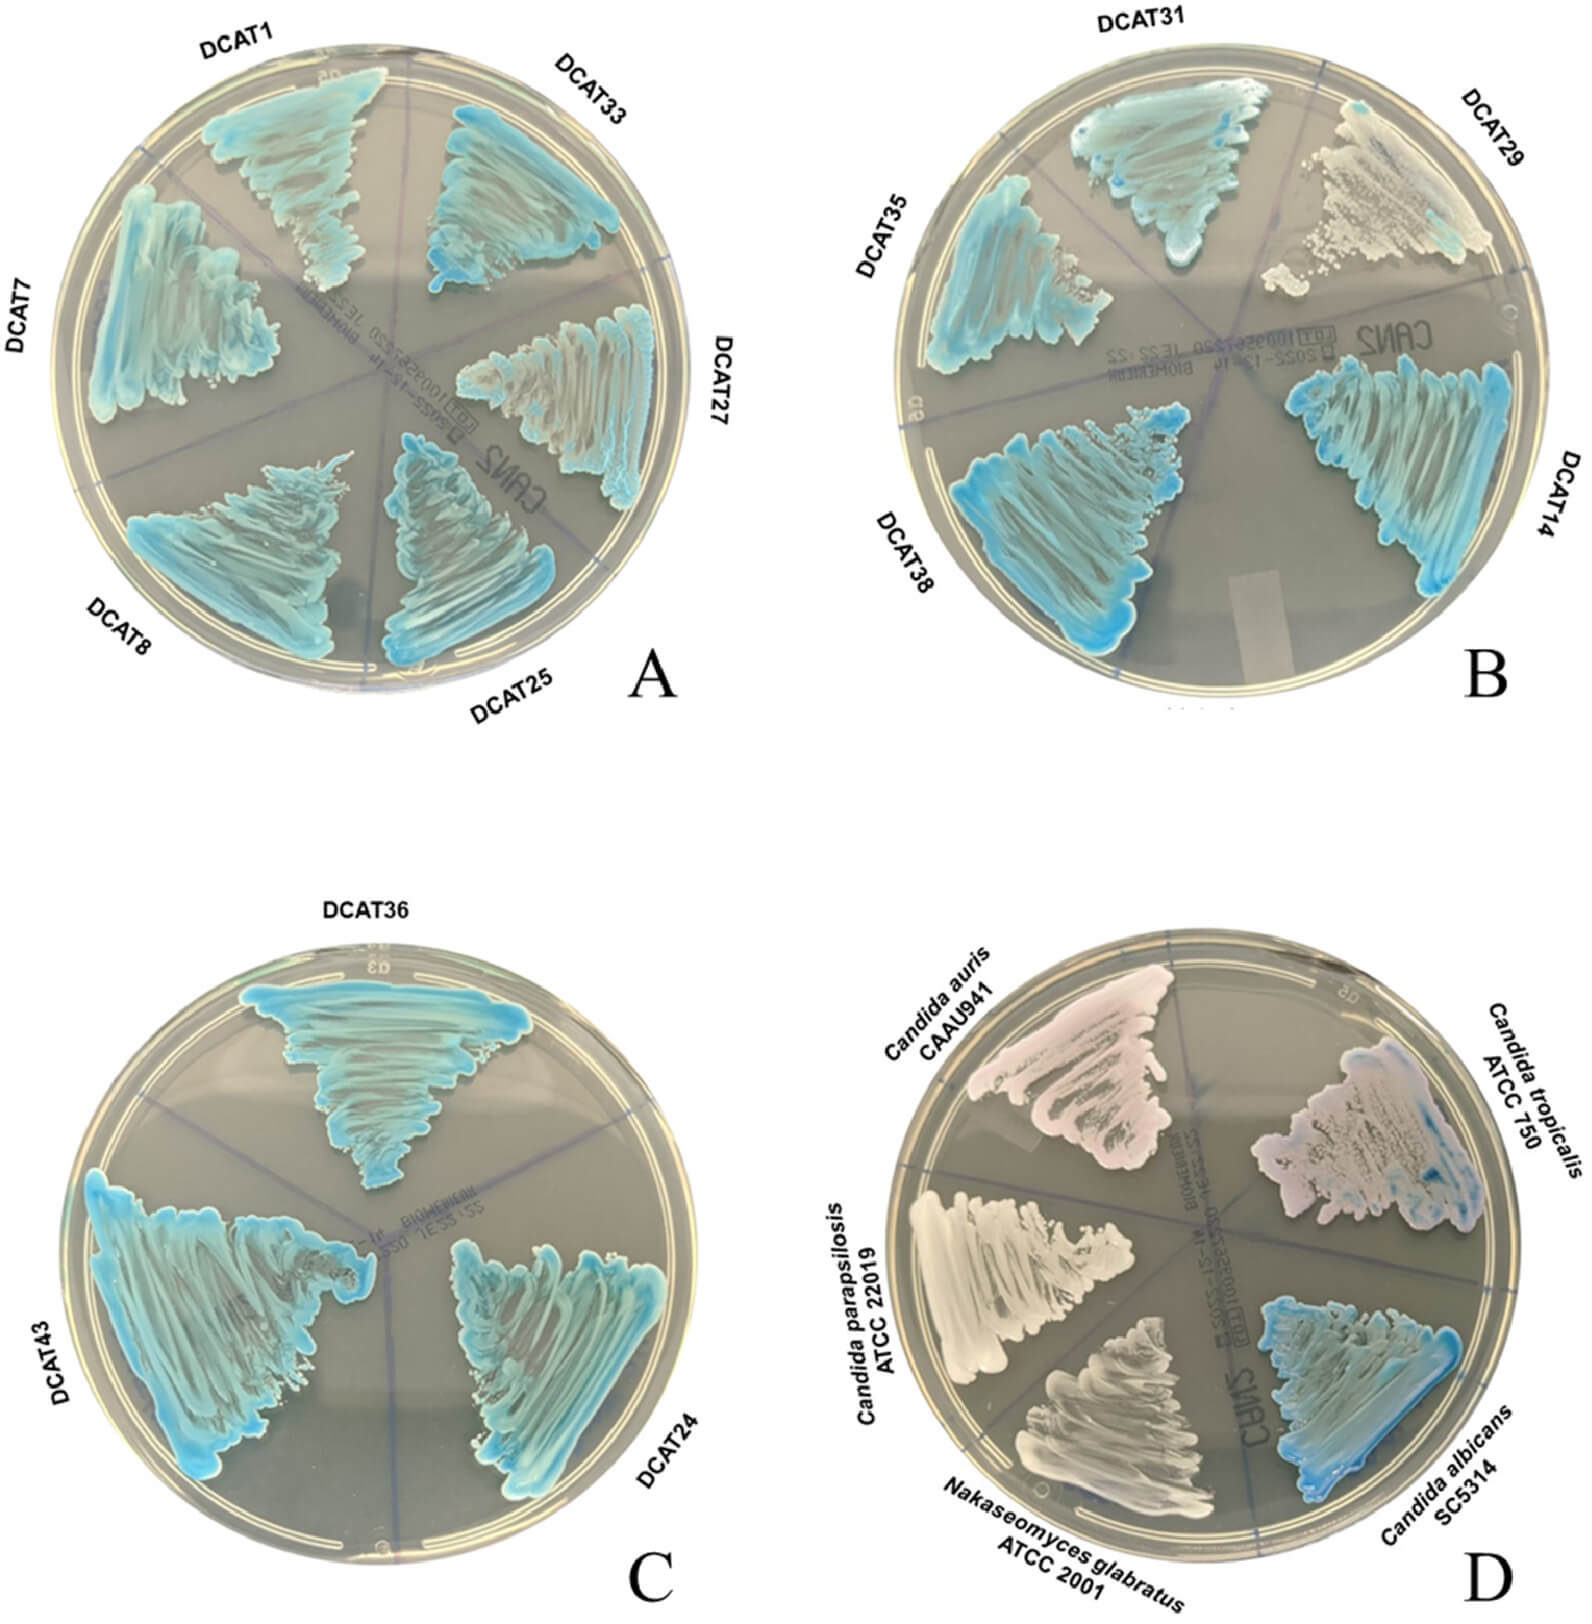
P301 | IICIMED
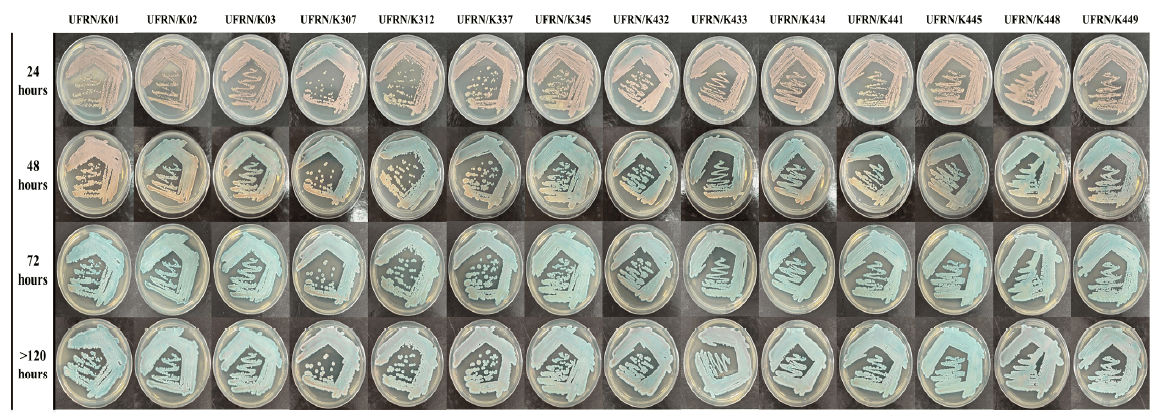
P296 | IICIMED

Estimated geographical distribution of T. indotineae in 2025. Heatmap representing the number of reported cases per country. Colour intensity reflects the number of reported T. indotineae cases in the literature.
P311
Mycoses. 2026, 69(4), e70170.
T. indotineae: A New Emergent Fungal Pathogen Driven by Global Travel.
https://doi.org/10.1111/myc.70170

Seven new 1,2,4-oxadiazol-5-ones show potent antileishmanial activity.
P310
Bioorg. Chem. 2026, 176, 109839.
Insights into a new class of antileishmanial compounds: an in vitro and in silico study of 1,2,4-oxadiazol-5(4H)-one derivatives.
https://doi.org/10.1016/j.bioorg.2026.109839

A new series of tetrahydroimidazo[1,2-a]pyrazine thiosemicarbazones was designed.
P309
Bioorg. Med. Chem. 2026, 139, 118678.
5,6,7,8-Tetrahydroimidazo[1,2-a]pyrazine-based thiosemicarbazones as anti-Trypanosoma cruzi agents.
https://doi.org/10.1016/j.bmc.2026.118678

P308
Gut Microbes, 2026, 18, 1.
Pre-existing β-lactamase gene diversity is associated with lower risk of ESBL-producing Enterobacterales colonization in patients exposed to ceftriaxone.
https://doi.org/10.1080/19490976.2026.2627692

P307
Journal of Applied Microbiology, 2026, 137, 3, lxag041.
Evaluation of Escherichia coli as a prophylactic treatment of intestinal colonization by extended-spectrum beta-lactamase-producing E. coli in a murine model of antibiotic-induced dysbiosis.
https://doi.org/10.1093/jambio/lxag041

cyp51A-mediated azole resistance mechanisms involved in Aspergillus fumigatus.
P306
JAC-Antimicrobial Resistance, 2026, 8, 1.
Global epidemiology of azole resistance in Aspergillus fumigatus.
https://doi.org/10.1093/jacamr/dlaf219

P305
Medical Mycology, 2025, 63, 12.
Multi-fungicide resistance in both clinical and environmental isolates of the human fungal pathogen Aspergillus fumigatus.
https://doi.org/10.1093/mmy/myaf110

P304
Sci Rep, 2025, 16, 2515.
Antifungal and fungicide susceptibility of clinical, animal, and environmental Fusarium and Neocosmospora species from Colombia: a one-health approach.
https://doi.org/10.1038/s41598-025-32234-0

Mapping of amino acid subs tu ons reported in Erg11, Tac1 and Mrr1, respec vely and their possible contribu on to fluconazole resistance
P303
npj Antimicrob. Resist., 2025, 3, 99.
Emerging antifungal resistance in Candida parapsilosis: the end of the innocence.
https://doi.org/10.1038/s44259-025-00173-5

P302
Inorg. Chem., 2025, 64, 16192-16203.
Synthesis and Biological Evaluation of Itraconazole Derivatives: Design in an Old Scaffold.
https://doi.org/10.1021/acs.inorgchem.5c02730
Macroscopic aspect of 14 Diutina catenulata and other species used as comparator strains when grown on CHROMID® Candida agar plates.
P301
J. Med. Mycol. 2025, 101583.
A One Health Perspective on Diutina catenulata: Phenotypic Traits, Stress Sensitivity, and Virulence Across Diverse Isolates.
https://doi.org/10.1016/j.mycmed.2025.101583

Binding position found by the GOLD docking programme for compound 30 in the ATP pocket of LmCK1.2. Hydrogen bonds are indicated by yellow lines.
P300
RSC Med. Chem. 2025, 16, 3746–3763.
Pharmacophore-guided optimization of the hit compound CTN1122 in the design of promising imidazo[1,2-a]pyrazine derivatives targeting the casein kinase 1 for antileishmanial therapy
https://doi.org/10.1039/D5MD00257E

P299
J. Antimicrob. Chemother. 2025, 80, 472-477.
Assessment of co-resistance to antibiotics recommended for acute pyelonephritis among Escherichia coli clinical strains from community- and nursing home-acquired urinary tract infections.
https://doi.org/10.1093/jac/dkae431

P298
JAMA Netw. Open. 2025, 8, e2521165.
Surgeons’ Contributions to Antibiotic Stewardship and Resistance Prevention.
https://doi.org/10.1001/jamanetworkopen.2025.21165

Prevalence of yeasts in four Brazilian states: Cear´a, Rio Grande do Norte, Minas Gerais and Mato Grosso do Sul.
P297
Sci. Total Environ. 2025, 973, 179139.
Antifungal resistance in yeasts from One Health perspective: A Brazilian study.
https://doi.org/10.1016/j.scitotenv.2025.179139
Variation of color and aspect of 14 Kodamaea ohmeri isolates on CHROmagar® Candida over time.
P296
Curr. Res. Microb. Sci. 2025, 8, 100359.
Kodamaea ohmeri: An emergent yeast from a One Health perspective.
https://doi.org/10.1016/j.crmicr.2025.100359

Schematic representation of the A. flavus CYP51 genes showing all mutations leading to amino acid substitutions previously reported in the literature.
P295
Mycoses. 2025, 68, e70051
Antifungal Resistance in Non-fumigatus Aspergillus Species.
https://doi.org/10.1111/myc.70051

P294
Mycopathologia. 2025, 190, 59.
Trichosporon and Antifungal Resistance: Current Knowledge and Gaps.
https://doi.org/10.1007/s11046-025-00969-z

Estimated phylogeny of 374 Candida parapsilosis isolates, constructed using 96,501 SNP sites.
P293
mBio. 2025, e01320-25.
Small pangenome of Candida parapsilosis reflects overall low intraspecific diversity.
https://doi.org/10.1128/mbio.01320-25

Mechanisms of action of agricultural fungicides according to FRAC classification.
P292
Sci. Total Environ. 2025, 1000, 180385.
Agrochemical fungicides as environmental drivers of antifungal resistance.
https://doi.org/10.1016/j.scitotenv.2025.180385